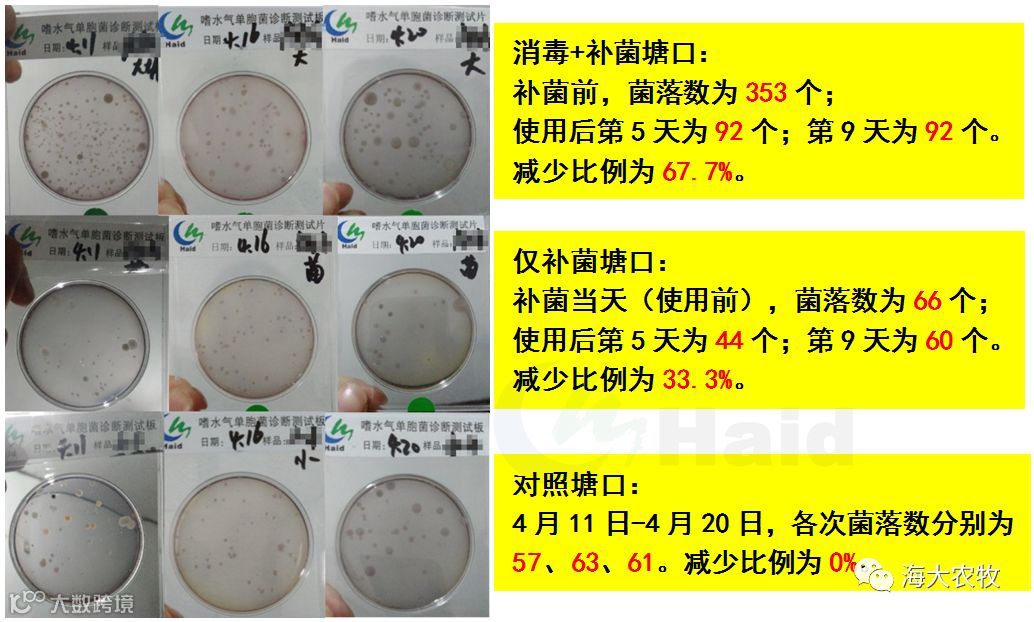

文 | 图 常州海大 苏溪阳、张亚辉
进入5月份,华东市场多数塘口已进入驯化阶段,但此时气候多变,是鲈鱼苗疾病爆发的阶段,更为甚者,部分塘口死亡率接近100%。为减少养殖户的损失,常州海大制定了三个针对性的预防措施,即内服3013+3505提升鱼体免疫力、聚维酮碘消毒减少病原体、泼洒鱼多宝发酵液改善池塘环境。
为跟进聚维酮碘、鱼多宝效果,常州海大鲈鱼项目组连续跟踪7个塘口20天,收集各塘口的菌相、水质数据,将实际效果呈现给广大客户。
1.1 实验设计
将跟踪的7个塘口分为3个实验组,分别为消毒+补菌组、补菌组、空白对照组:
(1)消毒+补菌组(3人):聚维酮碘消毒,用量为2亩*米/瓶;第二天再使用鱼多宝发酵液(1斤鱼多宝+1斤红糖+50斤消毒后的水发酵,发酵3-5天后,使用发酵液30斤/亩*米,每周泼洒一次)。
(2)补菌组(3人):仅使用鱼多宝发酵液,方法同上。
(3)空白对照组(1人):未使用方案的客户,过程无消毒、肥水、调水等操作。
1.2 数据跟踪
持续跟踪客户7人,跟踪指标包括:氨氮、亚盐、pH、池塘溶氧、藻类数量、底层水嗜水气单胞菌数量。跟踪日期为4月7日-4月20日,所有塘口均为苗塘,每4-5天跟踪1次,各个塘口跟踪时间为下午3-5点。
2.1 嗜水气单胞菌数量变化
分析所收集数据,得到鱼多宝发酵液的抑菌效果,具体如下(表1):
表1:鱼多宝前后的嗜水气单胞菌数量

使用的6位客户中,5位客户在补菌的4天后,开始显现效果,方案有效性为83.3%。鱼多宝内富含的乳酸杆菌,能分泌抗生物素类物质,对致病微生物具有拮抗作用,能够抑制嗜水气单胞菌等有害菌的生长;尤其是消毒后再补充鱼多宝发酵液,抑菌效果更明显(表1)。
使用发酵液第9天,部分塘口的嗜水气单胞菌数量有所反弹,为保证有害菌维持在低致病数量以下,需要每周泼洒1次保证抑菌效果,尤其是在疾病高发期。
2.2 三个实验组嗜水气单胞菌变化情况

图1:3个实验组嗜水气单胞菌变化
(1)使用聚维酮碘消毒再补菌的塘口, 4天后嗜水气单胞菌减少比例为53.3%;
(2)仅补充发酵液的塘口,嗜水气单胞菌减少比例为38.6%,比消毒+补菌客户低14.7%;
(3)未有补菌及消毒操作的塘口,嗜水气单胞菌数量无显著变化,细菌未减少。
2.3 客户使用案例(图2)
图2:客户使用案例
3.1 三个实验组pH变化情况
鱼多宝发酵液除抑菌效果外,还能通过补菌控藻,实现池塘水质稳定。

图3:3个实验组pH变化
消毒+补菌组及补菌组的客户在4月12日开始泼洒发酵液,使用后pH处于正常的波动范围(图3),且水质更加清爽。在使用发酵液之前,水中藻类以老藻为主,且杂质多;泼洒鱼多宝发酵液后,优势池塘有机碎屑减少,藻类活力提升,水色由发浑转嫩绿(图4)。

图4:客户泼洒鱼多宝后水质的变化情况
3.2 3个实验组溶氧变化情况

图5:3个实验组溶氧变化
同pH变化趋势一致,溶解氧也于正常范围内波动。在发酵完成的鱼多宝中,主要优势菌群为乳酸菌,乳酸菌容易在池塘中优势菌群。使用后,鱼多宝内的乳酸菌中含有分解大分子物质的菌株,起到维持pH、溶氧稳定的效果。
(1)对嗜水气单胞菌的抑制效果:使用聚维酮碘消毒再补菌(53.3%)>仅补菌(38.6%)>未补菌及消毒塘口(0%)。
(2)稳水效果:泼洒鱼多宝发酵液后,池塘有机质减少,藻类活力提升,提升水体稳定性。但受鱼多宝使用次数的影响,3个组变化幅度相近,需要提升使用频率,建议每周使用一次。
常州海大精彩文章


